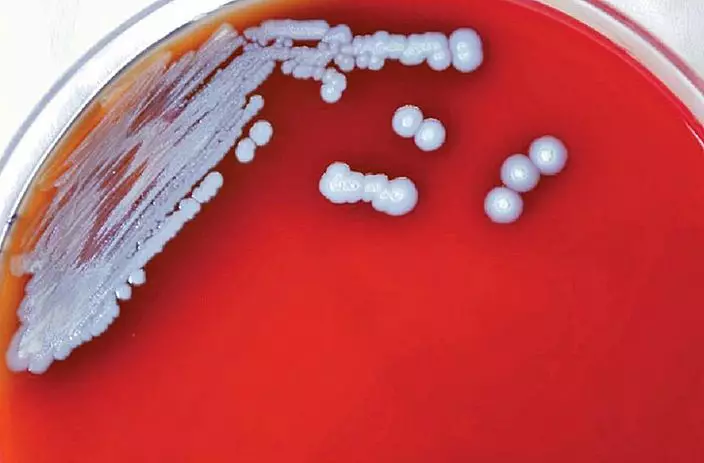

類鼻疽增加趨勢不容忽視。感染及傳染病科專科醫生曾祈殷表示,本港過去20年,共錄得過百宗人類感染類鼻疽的個案,但單在今年至目前為止,就已經發現近30宗,情況令人關注。他說,衛生當局暫時未在深水埗區發現任何環境因素,但區內短期內出現聚集式個案,值得尋根究柢。

感染及傳染病科專科醫生曾祈殷。資料圖片
曾祈殷在一個電台節目上解釋,類鼻疽細菌一般存活於潮濕及和暖的環境,較常出現在土壤中,打風或大雨後,有機會揚起含細菌的泥土,類鼻疽細菌要達攝氏76度才能徹底殺滅,因此亞熱帶地區會特別多個案。

今年至今共錄得29宗人類感染類鼻疽個案,當中20宗居於深水埗區。資料圖片
資料圖片
曾祈殷指,類鼻疽主要由吸入帶有細菌的微塵造成感染,他提醒市民在「翻風落雨」後,在街邊等車時要戴好口罩,以免吸入塵土。他又說,感染類鼻疽的早期病徵與感冒分別不大,潛伏期由1日至4星期不等,糖尿病、慢性腎病和肝病等長期病患者、免疫力不足人士、癌症患者及正服食抗排斥藥物或類固醇的人士,都屬於高危群組,一旦受感染,病情可能會急速惡化,死亡率可高達40至75%。

類鼻疽肆虐深水埗,本港今年發現29宗類鼻疽感染個案,當中20人居住深水埗區。小圖為曾祈殷醫生。








